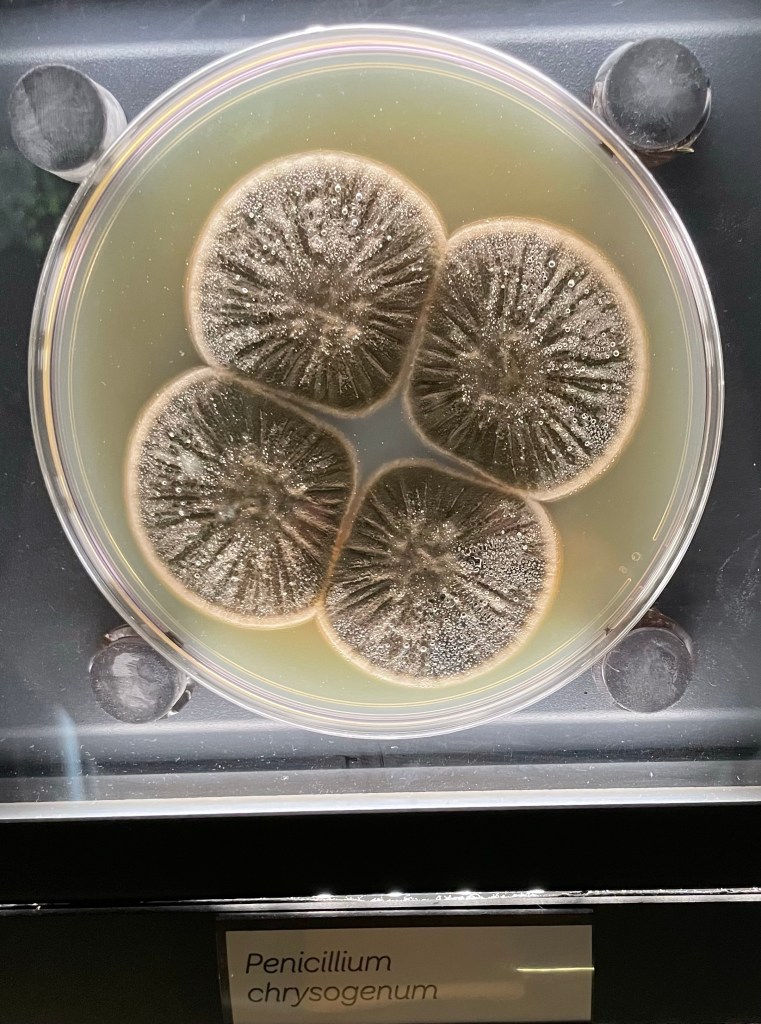
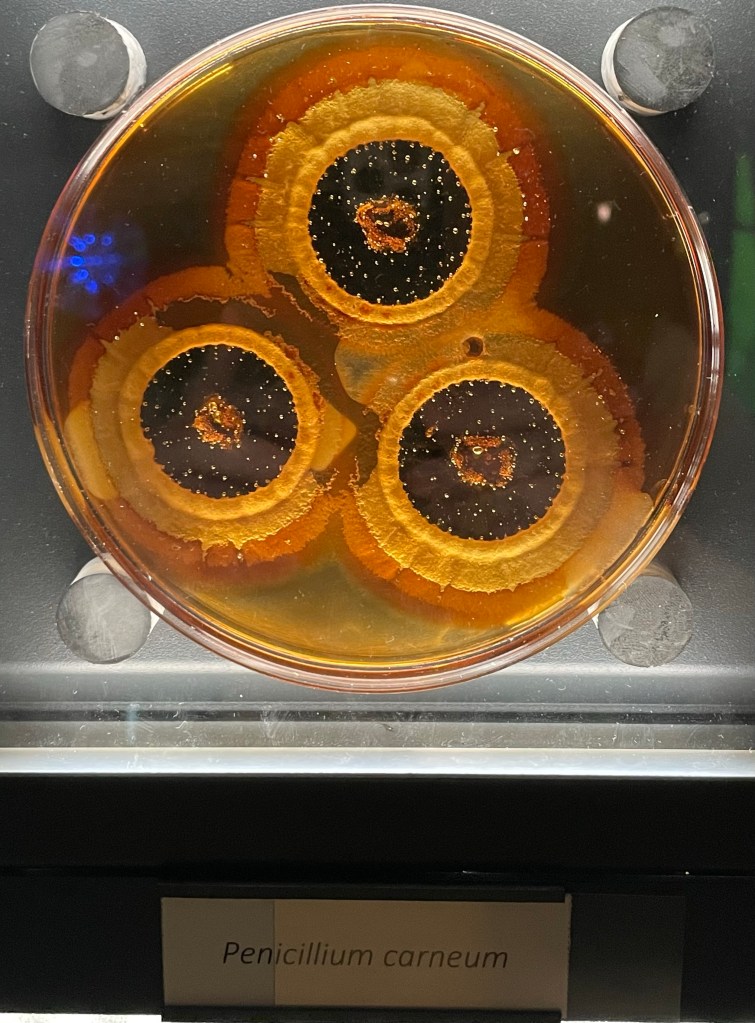

Our final day in The Netherlands was jam-packed with Overwhelming Mictobial Goodness (OMG), an acronym attributed to Mark O. Martin.
Mark and Ariane met at the Lab to ‘image’ the #luxart from yesterday’s session. Afterward we visited Leiden’s Saturday market. We now know the best places to buy bread, cheese, tarts, and fish. We sampled all the cheese along the way.




There were buskers throughout—like this gentleman making a sand sculpture in the street or the harp and flute duet.


But the real star of the day was the visit to Micropia, the microbiology museum in Amsterdam. Mark visited 5 years ago and loved it. What a treat to be able to share it with him today.

Ariane Briegel continues to be Hostess Extraordinaire. She packed a lot of adventure into our shortened visit. We are already making a list of things to do on our next visit—because there needs to be another!
It’s time to pack-up and get ready for early morning travels. Here’s hoping for trouble free adventures on our return home tomorrow.
Cover image is of leaf cutter ants at Micropia.